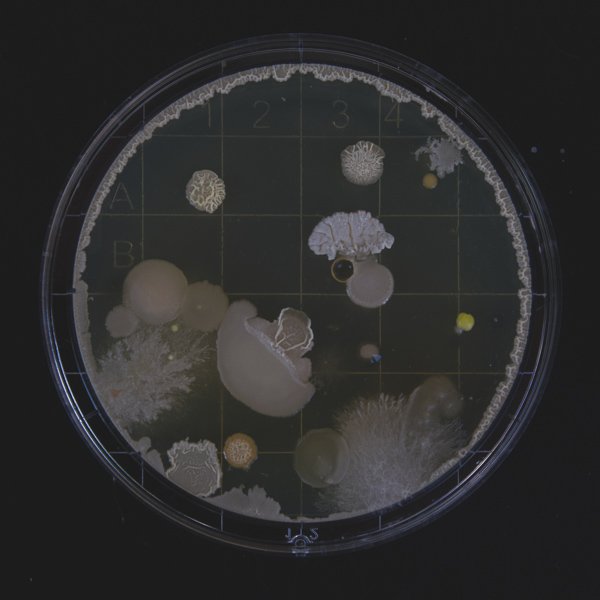
Mold: It Might Be Silently Destroying Your Health

Podcast Episodes
Archive
- Allergies 1
- Blood Chemistry 3
- Blood Sugar Management 3
- Bone Health 2
- CBD & Hemp 4
- Cancer 1
- Children's Health 4
- Diet and Nutrition 15
- Digestive Health 9
- EMF 3
- Energy 3
- Essential Oils 1
- Exercise 4
- Fat Loss 1
- Food 4
- Functional Medicine 10
- Gut Health 7
- Heart Health 7
- Hormonal Health 3
- Immune Health 17
- Inflammation 8
- Joint Health 1
- Memory 4
- Men's Health 6
- Mental Health 10
- Metabolism 1
- Muscle Mass 1
- Mushrooms 2
- Omega-3 2
- Pain 2
- Pet Health 4
- Pregnancy 2
- Protein 1
- Sexual Health 2
- Skin Care 3
- Sleep 7
- Stress & Anxiety 5
- Supplements 34
- Thyroid Health 3
- Toxins 1
- Weight Loss 5
- Women's Health 9